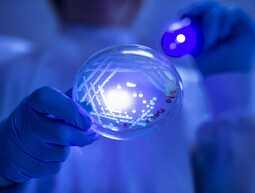

Browse Abstract
Subcategories of Abstract
List of access levels
-
 Abstract accommodation folder, containing 31 items
Abstract accommodation folder, containing 31 items -
 Abstract buildings folder, containing 42 items
Abstract buildings folder, containing 42 items -
 Abstract campus folder, containing 22 items
Abstract campus folder, containing 22 items -
 Abstract miscellaneous folder, containing 8 items
Abstract miscellaneous folder, containing 8 items -
 Abstract nature folder, containing 24 items
Abstract nature folder, containing 24 items -
 Abstract studying folder, containing 5 items
Abstract studying folder, containing 5 items -
Abstract subjects, research and equipment folder, containing 11 items
Abstract subjects, research and equipment folder, containing 11 items
